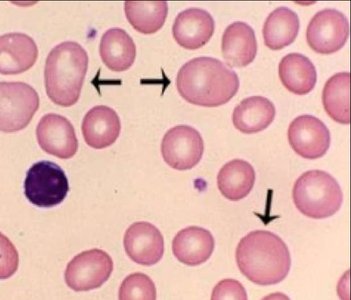
Iron-deficiency anemia blood smear
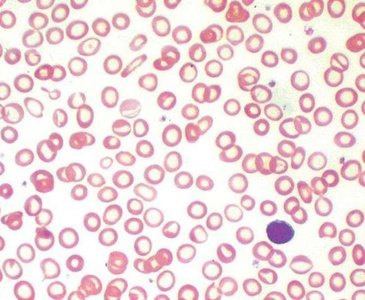
Pernicious anemia: megaloblastic cells

BackBlood: Structure, Function, and Disorders (Chapter 19 Study Notes)
Study Guide - Smart Notes
Tailored notes based on your materials, expanded with key definitions, examples, and context.
Blood: Structure, Function, and Disorders
Overview of Blood
Blood is a specialized liquid connective tissue that interacts with all other body systems. It plays essential roles in transportation, regulation, and protection within the human body.
Transportation: Delivers gases (O2, CO2), nutrients, and metabolic wastes.
Regulation: Maintains pH, temperature, and water content of tissues.
Protection: Provides immune defense and enables clotting to prevent blood loss.
Normal blood is more viscous than water and appears opaque. Its color ranges from bright scarlet (high O2) to brick red (low O2). Blood pH is tightly regulated between 7.35 and 7.45, and its temperature is about 38°C. Blood volume is approximately 8% of body weight (5–6 L in males, 4–5 L in females).
Components of Blood
Blood consists of cells (formed elements) and a liquid matrix (plasma):
Red Blood Cells (RBCs, Erythrocytes): ~44% of blood volume
White Blood Cells (WBCs, Leukocytes) & Platelets: ~1% (buffy coat)
Plasma: ~55% of blood volume; composed of ~90% water, ~9% proteins (albumins, globulins, fibrinogen, regulatory proteins), and ~1% solutes (nutrients, wastes, gases)


Red Blood Cells (Erythrocytes)
Structure and Function
Red blood cells are anucleate, biconcave discs that maximize surface area for gas exchange. They lack organelles, allowing more space for hemoglobin (Hb), the oxygen-carrying protein.
Count: ~5.4 million/μL of blood
Hemoglobin: Each molecule has 4 polypeptide chains (globins), each with a heme group containing iron that binds O2.
Lifespan: ~120 days


Hemoglobin Recycling and Erythrocyte Death
Worn-out RBCs are phagocytosed, mainly in the spleen. Hemoglobin is broken down: iron and amino acids are recycled, while waste components are excreted via the digestive and urinary systems.

Hematopoiesis and Erythropoiesis
Hematopoiesis is the formation of blood cells, occurring in red bone marrow. Hematopoietic stem cells (HSCs) can differentiate into any blood cell type. Erythropoiesis is the specific process of RBC production, regulated by erythropoietin (EPO) from the kidneys in response to hypoxia (low O2).
Requirements: Adequate iron, amino acids, and B vitamins
Stages: HSC → Erythrocyte-CFU → Proerythroblast → Early/Late Erythroblast → Reticulocyte → Mature Erythrocyte





Disorders of Red Blood Cells
Anemia
Anemia is a reduction in the oxygen-carrying capacity of blood, often due to decreased hemoglobin or RBC count.
Iron-deficiency anemia: Most common; insufficient iron for hemoglobin synthesis.
Pernicious anemia: Decreased RBC production due to vitamin B12 deficiency.
Sickle cell disease: Genetic disorder causing abnormal hemoglobin (HbS), leading to sickled, fragile RBCs and blockages in small vessels.

White Blood Cells (Leukocytes)
Types and Functions
Leukocytes are nucleated cells involved in immune defense. They leave circulation to combat infection and inflammation. Leukocytosis is an increase in WBCs, while leukopenia is a decrease. Leukemia is a cancer of WBCs, leading to excessive, abnormal cells in bone marrow.
Granulocytes:
Neutrophils: 3–5 lobed nucleus; phagocytic.
Eosinophils: Bi-lobed nucleus; combat parasitic worms.
Basophils: S-shaped nucleus; release histamine.
Agranulocytes:
Monocytes: U-shaped nucleus; become macrophages.
Lymphocytes: B cells (antibody production), T cells (cell-mediated immunity).

Leukopoiesis
Leukopoiesis is the formation of WBCs from hematopoietic stem cells. The lymphoid line produces lymphocytes, while the myeloid line produces other WBCs and RBCs. Bone marrow and cord blood transplants can treat blood disorders.
Platelets and Hemostasis
Platelets
Platelets are small, anucleate cell fragments derived from megakaryocytes. They circulate for 7–10 days and are essential for blood clotting.
Count: 250,000–400,000/μL
Function: Promote clotting by releasing proteins and forming platelet plugs
Hemostasis
Hemostasis is the process of stopping bleeding through three sequential steps:
Vascular spasm: Immediate vasoconstriction of damaged vessels
Platelet plug formation: Platelets adhere to exposed collagen and each other
Coagulation: Clot formation via activation of clotting factors and conversion of fibrinogen to fibrin
Clot Formation and the Clotting Cascade
Clotting involves a cascade of reactions:
Formation of prothrombinase (via extrinsic or intrinsic pathways)
Conversion of prothrombin to thrombin
Thrombin converts fibrinogen to fibrin, forming the clot
Clots are retracted and dissolved after healing.
Blood Groups and Typing
Antigens and Blood Groups
Blood groups are defined by the presence of specific antigens on RBC membranes and corresponding antibodies in plasma. Agglutination (clumping) occurs when incompatible antigens and antibodies bind, potentially causing hemolysis and death.
Type O: Universal donor (no antigens on RBCs)
Type AB: Universal recipient (no antibodies in plasma)
Blood typing uses antisera to identify blood type and ensure compatibility for transfusions.
Rh Factor and Hemolytic Disease of the Newborn
The Rh factor is another antigen on RBCs. Rh+ individuals have the antigen; Rh– individuals do not. Normally, blood does not contain anti-Rh antibodies. Hemolytic disease of the newborn can occur if an Rh– mother develops antibodies against Rh+ fetal blood, affecting subsequent pregnancies.
Summary Table: Main Components of Blood
Component | Percentage of Blood | Main Function |
|---|---|---|
Plasma | ~55% | Transport of nutrients, wastes, hormones, proteins |
Red Blood Cells (Erythrocytes) | ~44% | Oxygen and carbon dioxide transport |
White Blood Cells (Leukocytes) | ~1% (with platelets) | Immune defense |
Platelets | ~1% (with WBCs) | Blood clotting |
Key Equations
Oxygen Carrying Capacity:
Hematocrit: